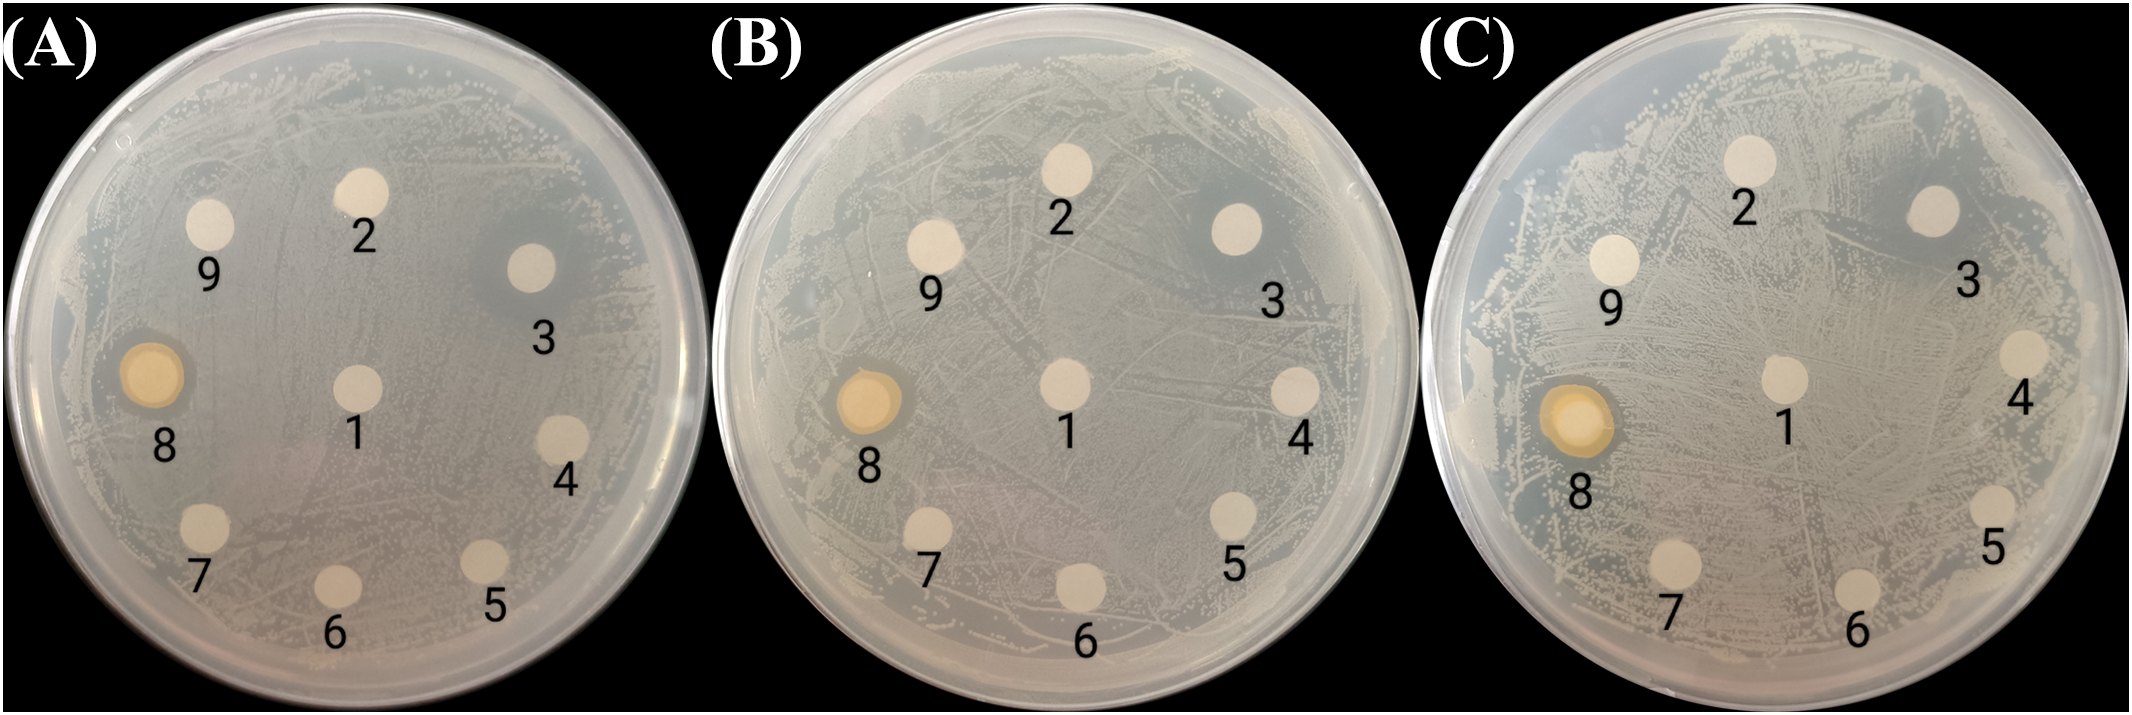

Abstract
Vibrio disease is a prevalent bacterial infection in aquaculture, and using bacteria with antagonistic properties against Vibrio species as probiotics has emerged as a promising method for disease prevention. Additionally, low biomass productivity of microalgae feed remains a significant bottleneck in bivalve aquaculture. Therefore, it is essential to screen for bacteria that both enhance microalgae growth and inhibit Vibrio pathogens. In this study, seven bacterial strains capable of promoting microalgae growth were screened for their ability to inhibit three Vibrio pathogens, i.e., Vibrio vulnificus, Vibrio parahaemolyticus and Vibrio cholerae, and thus serve as a dual-functional probiotic for aquaculture. The antagonistic mechanism of these bacteria was further investigated by analyzing the inhibitory effects of their extracellular products (ECP) on Vibrio species. Results indicated that Pseudoalteromonas flavipulchra exhibited antagonistic effects against all three Vibrio species tested. The ECP of P. flavipulchra displayed stable antibacterial activity, though this ability was lost after the ECP was treated with heat, alkali, or proteinase K. The proteinaceous fraction isolated from the ECP by precipitation with 90% saturated ammonium sulfate demonstrated concentration-dependent antibacterial activity. These findings suggest that P. flavipulchra could serve as a promising dual-functional probiotic for aquaculture, warranting further research to optimize its application in this field.
1 Introduction
Due to high-density farming, modern aquaculture is increasingly beleaguered by frequent disease outbreaks that cause substantial losses (Jin et al., 2024). Vibriosis is one of the most prevalent diseases in aquaculture and it affects marine fish, shellfish, crustaceans, and many other species. Common pathogenic Vibrio species include Vibrio parahaemolyticus, Vibrio alginolyticus, Vibrio harveyi, etc. Among Vibrio pathogens, Vibrio vulnificus is considered as the most virulent, and it causes significant mortality in the aquaculture of Cynoglossus semilaevis (Hu et al., 2020; Oliver, 2006). Infections caused by V. parahaemolyticus create a health risk to humans through the consumption of contaminated seafood (Osborne et al., 2023). Vibrio pathogens produce toxins that can lead to acute hepatopancreatic necrosis disease (AHPND) in bivalves and crustaceans (López-Cervantes et al., 2021), and the AHPND induced by V. parahaemolyticus is one of the most devastating diseases in the global shrimp aquaculture industry (Jun et al., 2017).
The prevention and management of vibriosis in aquaculture has long relied on the use of antibiotics, but the selective pressure due to the excessive use of antibiotics has created persistent antibiotic-resistant bacteria that are spreading rapidly. The situation calls for a shift in disease management strategies to ensure environmental and food safety and protect the aquaculture industry (Yilmaz et al., 2022). Probiotics are now recognized as a safe and effective alternative for controlling aquatic diseases. In shellfish aquaculture, various probiotics that can inhibit Vibrio growth, improve host health, and reduce disease incidence have been identified. For instance, Phaeobacter inhibens S4 can protect larval eastern oysters from pathogenic Vibrio infections without affecting growth (Takyi et al., 2024). Similarly, the addition of the probiotic Bacillus pumilus RI06-95 to a hatchery of eastern oyster larvae provides protection against Vibrio coralliilyticus RE22 (Stevick et al., 2019), since it alters the abundance and composition of Vibrio populations and decreases the relative abundance of pathogenic species. Muñoz-Cerro et al. isolated three probiotic strains from the scallop veliger larvae exhibiting antibacterial activity against Vibrio bivalvicida in vitro and found that they protect the larvae against infection (Muñoz-Cerro et al., 2023).
Microalgae are a key food source in aquaculture because they are rich in proteins, polyunsaturated fatty acids, vitamins, and other valuable nutrients (Nagappan et al., 2021), and species such as Isochrysis sp., Nannochloropsis oculata, Skeletonema sp., Phaeodactylum tricornutum, and Chlorella sp. are widely used as microalgae feed (Zhang et al., 2023). However, the current bivalve aquaculture industry is limited by the biomass productivity of microalgae feed, as the growth of the algae struggles to catch up with the escalating need of the expanding bivalve aquaculture. The algae-bacteria relationship and its impact on ecosystems are now hot research areas. Recent studies found that some bacteria can strongly enhance the biomass productivity of microalgae. For example, Sphingobacteria and Flavobacteria isolated from Nannochloropsis oceanica have been shown to promote the growth of N. oceanica and increase the accumulation of eicosapentaenoic acid (EPA) in the algae (Liu et al., 2020). Analogously, Algoriphagus sp. and Oceanicaulis sp. enhance the growth of Isochrysis galbana and boost the content of docosahexaenoic acid (DHA) in the algae (Wu et al., 2023). Most studies focused on the effects of bacteria on the growth and metabolism of microalgae themselves to screen microalgae growth-promoting bacteria (MGPB). However, these MGPB will also enter the bivalve aquaculture systems, along with the microalgae feed, and their impact on shellfish culture systems deserves attention, particularly with regard to antagonistic effects on pathogenic vibrios (Di Costanzo et al., 2023; Li et al., 2023; Seymour et al., 2017). Therefore, it is essential to screen for microalgae growth-promoting bacteria (MGPB) that can both promote the microalgae growth and inhibit pathogenic vibrios. This would not only improve microalgae biomass yield but also promote the healthy development of shellfish larvae.
While there has been considerable research on probiotics in aquaculture, the antagonistic effects of phycospheric bacteria on Vibrios pathogens are scarcely studied. In this study, seven MGPB were screened for antibacterial activity against three major pathogenic Vibrio species, namely V. vulnificus, V. parahaemolyticus and Vibrio cholerae. The antibacterial substances produced by the MGPB were further investigated and analyzed. Through co-cultivating microalgae and bacteria, this study aims to enhance the microalgae growth while effectively inhibiting the proliferation of pathogenic vibrios. The use of MGPB with Vibrio antagonism could provide a foundation for the future biological control of bacterial diseases in aquaculture.
2 Material and methods
2.1 Culture of microalgae and bacteria
The I. galbana strain (NMBjih021-2) used in this study was obtained from the Marine Biotechnology Laboratory of Ningbo University, China. The microalgae were cultured in NMB3 medium (Peng et al., 2020), which contained KNO3 (100 mg/L), KH2PO4 (10 mg/L), MnSO4·H2O (2.5 mg/L), FeSO4·7H2O (2.5 mg/L), EDTA-Na2 (10 mg/L), vitamin B1 (6 mg/L), and vitamin B12 (0.05 mg/L). The microalgae were cultivated at 25°C with a 12 h/12 h light/dark cycle in a light-controlled incubator (GXZ-280B, China), and the light intensity was 100 μmol photon m−2 s−1. Axenic I. galbana was maintained as described by Cao et al. (2019).
Seven bacterial strains, i.e., Alteromonas sp., Oceanicaulis sp., Dinoroseobacter sp., Pseudoalteromonas flavipulchra, Alteromonas macleodii, Marinobacter sp., and Bacillus jeotgali, were isolated from the cultures of I. galbana in the exponential growth phase (Supplementary Table S1, Supplementary Figure S1). Vibrio vulnificus, V. parahaemolyticus and V. cholerae were isolated from the water samples collected at the Dalai Experimental Base in the Luoyuan County of Fujian, China (Supplementary Table S1, Supplementary Figure S2). All bacteria were freshly plated on 2216E agar plates in a biochemical incubator (SPX-50, China) and grown in 2216E medium at 28°C with shaking at 220 rpm in a thermostatic shaking incubator (THZ-103B, China).
2.2 Co-culture experiment
The cultures of the seven bacterial strains (OD600 = 0.4–0.6) were centrifuged at 8,000 rpm for 7 min and washed twice with sterile NMB3 medium, and the collected bacteria were added to the axenic culture of I. galbana in the exponential phase, whose cell density was approximately 1 × 106 cells/mL, to give a co-culture with a bacteria/algae ratio of 1:1. The mixture was cultivated at 25°C for 14 days under fluorescent light (4000 lux) with a 12 h/12 h light/dark cycle, and the algal growth was assessed every two days by cell counting (Qin et al., 1999). All experiments were carried out in triplicate. Axenic I. galbana culture was used as the control.
2.3 Screening bacterial strains for Vibrio antagonism
The seven bacterial strains were tested for their antagonistic activities against V. vulnificus, V. parahaemolyticus, and V. cholerae using the disc diffusion method (Bauer et al., 1966). The isolates of the seven bacterial strains were prepared in a liquid 2216E medium, and sterilized filter paper discs were soaked in the culture medium of the bacterial strains for 1 h. The discs were then spread on plates containing solidified 2216E medium that was pre-inoculated with fresh Vibrio spp. cultures (100 µL, about 24 h old). The growth inhibition zones (GIZ) around each disc were measured after incubation at 28°C for 24–48 h. Cephalosporin and 2216E liquid medium were used as the positive and negative controls, respectively. To further verify the inhibitory effect of the bacteria on Vibrio growth, the co-cultures of Vibrio spp. with the bacterial strains were incubated in 2216E liquid medium at 28°C for 24 h. The cultures from each group were sampled and spread evenly on thiosulfate citrate bile salts sucrose agar plates, and the colonies of Vibrio spp. were counted.
2.4 Isolation and analysis of the extracellular products (ECP) of P. flavipulchra
The culture of P. flavipulchra was centrifuged (TGL-18M, China) at 4°C and 8000 rpm for 10 min, and the supernatant was passed through a sterilized 0.22 µm Millipore filter. The obtained solution of the P. flavipulchra ECP was stored at 4°C until use. To measure the inhibitory effect of the ECP on Vibrio spp., a 1:1 v/v mixture of the ECP solution and the culture of Vibrio spp. was prepared. The mixture was incubated at 28°C with shaking at 220 rpm, and OD600 was measured every 3 h using a spectrophotometer (TU-180, China). The control group used the mixture of 2216E liquid medium and the culture of Vibrio spp. To evaluate the effect of ECP concentration on inhibition effect, the ECP solution (1–6 mL) was added into the culture of Vibrio spp. (10 mL). The mixtures were incubated at 28°C with shaking at 220 rpm, and OD600 was measured using a spectrophotometer every 3 h up to 24 h. The control group used the Vibrio spp. culture alone with the addition of ECP.
2.5 Sensitivity of antibacterial substance to heat, alkali, and proteinase K treatment
The following treatments were applied separately to the P. flavipulchra ECP: (1) heating at 100°C in a water bath for 30 min, (2) adjustment of the solution pH 12 using 3 M NaOH, (3) incubation with proteinase K (1 mg/mL) at 37°C for 2 h. After adjusting to pH 7 (if needed), the treated ECP was then added to Vibrio spp. cultures to assess the antibacterial activity.
2.6 Precipitation of proteins from P. flavipulchra ECP
Proteins were isolated from the P. flavipulchra ECP through ammonium sulfate precipitation using a solution of (NH4)2SO4 at 70%, 80%, or 90% saturation. The mixture was maintained at 4°C for 12 h, then centrifuged at 4°C and 8,000 rpm for 10 min. The collected precipitates were resuspended in phosphate-buffered saline (PBS) and dialyzed using a dialysis membrane. The antibacterial activity of the dialysate was tested by adding it to the culture of Vibrio spp. The mixture was incubated at 28°C with shaking at 220 rpm for 24 h, and OD600 was measured using a spectrophotometer. The precipitates obtained using 90% ammonium sulfate were subsequently added into the culture of Vibrio spp. at varying concentrations, and the antibacterial activity was measured.
2.7 Statistical analysis
Statistical analysis was carried out using SPSS 22.0 (SPSS Inc., USA). All experiments were run in three replicates, and the mean value and standard deviation were calculated accordingly. Differences were considered statistically significant when P < 0.05.
3 Results
3.1 Effects of the seven bacterial strains on I. galbana growth
All seven bacterial strains effectively promoted the growth of I. galbana. Oceanicaulis sp. and Marinobacter sp. significantly promoted the growth of I. galbana starting from day 2, whereas B. jeotgali, Alteromonas sp., P. flavipulchra, and A. macleodii promoted the microalgae growth starting from day 4. Dinoroseobacter sp. enhanced the growth of I. galbana starting from day 8 (Figure 1). The growth of axenic I. galbana started to plateau after day 6, but the growth of I. galbana co-cultured with bacteria either did not slow down over the 14-day experimental period or had an inflection point at a much later time.
Figure 1

Effects of seven phycospheric bacterial strains on the growth of Isochrysis galbana.(A)Bacillus jeotgali, (B)Oceanicaulis sp., (C)Dinoroseobacter sp., (D)Alteromonas sp., (E)Pseudoalteromonas flavipulchra, (F)Marinobacter sp., (G)Alteromonas macleodii. Error line represented standard deviation (SD), * represented significant difference, p < 0.05.
3.2 Screening bacterial strains with Vibrio antagonism
All seven bacterial strains were further tested for their antagonistic activities against V. vulnificus, V. parahaemolyticus, and V. cholerae using the disc diffusion method. Only the discs soaked with P. flavipulchra or cephalosporin produced clear growth inhibition zones (Figure 2), suggesting that P. flavipulchra was the only bacterial strain that suppressed the growth of V. cholerae, V. vulnificus, and V. parahaemolyticus. To further verify the inhibitory effect of the bacteria on Vibrio growth, the co-cultures of Vibrio spp. with different bacterial strains were grown in 2216E liquid medium. The cell densities of V. cholerae, V. vulnificus, and V. parahaemolyticus were significantly reduced compared to the control upon co-culturing with P. flavipulchra (Figure 3). The results corroborated the findings from the disc diffusion screening and confirmed that P. flavipulchra could inhibit V. cholerae, V. vulnificus, and V. parahaemolyticus.
Figure 2
Screening bacteria with Vibrio antagonism against (A)Vibrio vulnificus, (B)Vibrio cholerae, and (C)Vibrio parahaemolyticus using the disc diffusion method. The discs were (1) 2216E (negative control), (2) Alteromonas macleodii, (3) cephalothin (positive control, 0.1 mg/mL), (4) Bacillus jeotgali, (5) Oceanicaulis sp., (6) Dinoroseobacter sp., (7) Alteromonas sp., (8) Pseudoalteromonas flavipulchra, and (9) Marinobacter sp.
Figure 3

Analysis of Vibrio antagonism of seven phycospheric bacterial strains co-cultured with (A)Vibrio vulnificus, (B)Vibrio cholerae, and (C)Vibrio parahaemolyticus. Error line represented standard deviation (SD), * represented significant difference, p < 0.05.
3.3 The antibacterial activity of the P. flavipulchra ECP
To further analyze whether antibacterial activity of P. flavipulchra is due to the secretion of extracellular antibacterial substances, the P. flavipulchra ECP was added to Vibrio spp. cultures. The growth of V. vulnificus, V. cholerae, and V. parahaemolyticus was significantly inhibited by the addition of the P. flavipulchra ECP (Figures 4A–C), and the inhibitory effect increased with rising ECP concentrations. The inhibition rate reached 35.2%, 18.1%, and 30.7% for V. vulnificus, V. cholerae, and V. parahaemolyticus, respectively, when 6 mL ECP was added into 10 mL Vibrio culture (Figures 4D–F).
Figure 4

Analysis of antagonism of Pseudoalteromonas flavipulchra extracellular products (ECP) against (A, D)Vibrio vulnificus, (B, E)Vibrio cholerae, (C, F)Vibrio parahaemolyticus. Error line represented standard deviation (SD), * represented significant difference, p < 0.05.
3.4 Effects of heat, alkali and proteinase K treatments on the antibacterial activity of the P. flavipulchra ECP
Next, V. parahaemolyticus was selected as a representative substrate to analyze the effects of heat, alkali, and proteinase K treatments on the antibacterial activity of the P. flavipulchra ECP (Figure 5). The P. flavipulchra ECP completely lost its antibacterial activity against V. parahaemolyticus after it was heated, exposed to alkali, or treated with proteinase K. Thus, the antibacterial substance in the ECP of P. flavipulchra likely had proteinaceous characteristics.
Figure 5

Effects of (A) heat, (B) alkali and (C) proteinase K treatments on the antibacterial activity of the Pseudoalteromonas flavipulchra ECP. Error line represented standard deviation (SD), * represented significant difference, p < 0.05.
3.5 The antibacterial activity of the proteins isolated from the P. flavipulchra ECP
To further determine whether the antibacterial substances in P. flavipulchra ECP are proteins, the proteins in the P. flavipulchra ECP were isolated by precipitation using ammonium sulfate. The proteins precipitated using 90% ammonium sulfate had the highest antibacterial activity and were used for further assessments (Figure 6A). Further testing of these protein fractions revealed a concentration-dependent increase in antibacterial activity against on V. parahaemolyticus, demonstrating that higher protein concentrations enhanced the antibacterial effect (Figure 6B).
Figure 6

The antibacterial activity of the proteins precipitated from the Pseudoalteromonas flavipulchra ECP. (A) The antibacterial activity of proteins precipitated using ammonium sulfate at different levels of saturation. (B) The antibacterial efficacy from using rising amounts of the proteins precipitated with ammonium sulfate at 90% saturation. Error line represented standard deviation (SD), * represented significant difference, p < 0.05.
4 Discussion
4.1 The importance of microalgae growth-promoting bacteria
To date, many MGPB have been identified. They demonstrate important regulatory effects on the growth and metabolism of microalgae. For instance, co-culturing Pseudomonas putida and Chlorella vulgaris significantly increases the cell density of C. vulgaris (Shen et al., 2017), and Rhizobium strain 1011 enhances the chlorophyll levels and lipid content in microalgae by supplying vitamin B12 (Do Nascimento et al., 2013). Nevertheless, the impact of MGPB on the aquaculture animals feeding on microalgae is underexplored, particularly concerning their antagonistic effects against Vibrio species. This work thus aimed to screen MGPB capable of Vibrio antagonism and analyze the antibacterial substances from the MGPB.
4.2 The role of probiotics in disease prevention in aquaculture
Vibrio species are widely recognized as the major causes of mass mortality in marine aquaculture (Wang et al., 2022). Although antibiotics have long been employed to prevent Vibriosis, the excessive application of antibiotics has led to environmental degradation and the emergence of antibiotic-resistant bacteria (Rico et al., 2017). This situation has heightened the need for alternative approaches. Probiotics have emerged as a promising option for disease prevention in aquaculture (Dawood and Koshio, 2016; Lieke et al., 2020; Wang et al., 2008; Doan et al., 2020). Recent studies have demonstrated that probiotics can improve growth performance (Li et al., 2024), enhance immunological responses (Costa et al., 2024), and inhibit pathogenic microorganisms (Wang et al., 2020a). However, most studies on probiotics focus on the isolation and screening of bacterial strains from healthy aquaculture animals, and limited attention is given to the antagonistic effects of MGPB against pathogens such as Vibrio species. The present study revealed that P. flavipulchra simultaneously promoted the growth of I. galbana and inhibited V. vulnificus, V. cholerae, and V. parahaemolyticus, suggesting that it might be a promising probiotic for shellfish aquaculture. Nevertheless, the application of P. flavipulchra as a probiotic in aquaculture faces several challenges. For instance, variations in environmental conditions, such as temperature and salinity, can influence the activity and survival of the bacterium, and further study is needed to evaluate if P. flavipulchra can maintain its anti-Vibrio activity despite these fluctuations. In addition, it may not be straightforward to deliver P. flavipulchra in a way that ensures high survival and activity, and methods like freeze-drying or incorporation into the shellfish feed may reduce bacterial viability. Therefore, the application of P. flavipulchra as a probiotic in aquaculture still requires additional investigation.
4.3 Mechanisms of P. flavipulchra antagonism against Vibrio species through antibacterial substances
Several mechanisms have been proposed for the inhibition of various Vibrio species by probiotics, including competition for adhesion sites, competition for nutrients, immune system stimulation, disruption of quorum sensing (QS), and production of inhibitory substances (Alcaide et al., 2005; Chauhan and Singh, 2019). Most commonly, the probiotics synthesize and secrete antibiotics, antibacterial agents, lysozymes, proteases, bacteriocins, butyric acid, small molecules, or organic acids that have antibacterial properties (Kesarcodi-Watson et al., 2008; Wang et al., 2019). For example, Weissella cibaria KY10 completely inhibits the growth of V. parahaemolyticus T11.1 through the secretion of various antibacterial substances, primarily organic acids (Kanjan et al., 2022). Bacillus subtilis produces amicoumacin A to inhibit the growth of V. parahaemolyticus and other Vibrio species, thereby reducing the risk of vibriosis outbreaks (Wang et al., 2020b; Chen et al., 2024). Lactobacillus plantarum W2 inhibits seven pathogenic bacteria, including V. parahaemolyticus, and organic acids are believed to be active antibacterial agents (Wei et al., 2022). In this study, the ECP isolated from P. flavipulchra exhibited antibacterial effects against V. parahaemolyticus, but its potency was lost after treatment with heat, alkali, or proteinase K. Analogously, Fontoura et al. reported that the purified antibacterial substance from Pseudomonas sp. strain 4B is partially inactivated by proteinase K or trichloroacetic acid and suggested that a protein moiety is involved in the antibacterial activity (Fontoura et al., 2008). Thus, the antibacterial substances in the ECP of P. flavipulchra are likely proteinaceous.
Many studies have demonstrated that bacteria can produce proteinaceous substances to inhibit Vibrio species. For instance, Lactobacillus sp. M31 produces a novel iturin, known as iturin V, which exhibits antibacterial activity against Vibrio species (Singh et al., 2021). Pseudoalteromonas sluteoviolacea produces a 100 kDa protein that possesses L-amino acid oxidase activity and exerts antibacterial activity against Vibrio species such as V. parahaemolyticus (Gómez et al., 2008). Pseudoalteromonas sp. strain X153 generates an 87 kDa antimicrobial protein that can protect bivalve larvae against Vibrio (Longeon et al., 2004). In this study, the proteins precipitated from the ECP of P. flavipulchra using 90% ammonium sulphate exhibited strong antibacterial activity and inhibited the growth of V. parahaemolyticus in a concentration-dependent manner. However, further investigation is needed to identify and fully characterize the exact protein responsible for the antibacterial property.
4.4 Emerging antibacterial mechanisms of Pseudoalteromonas
Pseudoalteromonas is garnering increasing attention in aquaculture due to its ability to produce a myriad of antibacterial compounds, including chitinase, pigments, and antibiotics (Bosi et al., 2017; Richards et al., 2017). In addition, P. flavipulchra has been noted to produce vesicle-like structures, which may be involved in some novel antibacterial mechanism (Wang et al., 2021). Vibrio spp. typically use QS to regulate virulence, biofilm formation, bioluminescence, sporulation, swarming motility, host colonization, and other population behaviors (Milton, 2006). Pseudoalteromonas sp. strain DL3 exhibits not only broad-spectrum antibacterial activity but also the ability to quench QS signal molecules (Zhao et al., 2023). Xu et al. reported that healthy cuttlefish harbored both the pathogenic V. alginolyticus and the antagonistic Pseudoalteromonas piscicida and attributed the inhibition of V. alginolyticus to chemotaxis rather than the production of antibacterial substances (Xu et al., 2024). While the ECP of P. flavipulchra contained proteinaceous material that was antimicrobial, further research is necessary to find out whether P. flavipulchra also utilizes other mechanisms to inhibit Vibrio species.
5 Conclusion
This study demonstrated the potential of P. flavipulchra as a dual-functional probiotic for aquaculture, with both antibacterial activity against Vibrio pathogens and the ability to promote microalgae growth. The antagonistic effects of P. flavipulchra against V. vulnificus, V. parahaemolyticus, and V. cholerae were likely mediated by the proteinaceous compounds in the extracellular products, as the antibacterial activity was lost after exposure to heat, alkali, or enzymatic degradation. The concentration-dependent antibacterial efficacy of the purified substances underscored their potential use in disease prevention. It seems rewarding to further investigate if P. flavipulchra can be applied as a probiotic to create healthier and more productive aquaculture systems, thanks to its ability to both inhibit Vibrio pathogens and improve microalgal biomass productivity.
Statements
Data availability statement
The raw data supporting the conclusions of this article will be made available by the authors, without undue reservation.
Author contributions
M-NW: Conceptualization, Data curation, Investigation, Writing – original draft. Y-JX: Data curation, Investigation, Writing – original draft. M-MS: Data curation, Writing – review & editing. Z-YW: Data curation, Writing – review & editing. J-YC: Conceptualization, Funding acquisition, Resources, Supervision, Writing – review & editing. J-LX: Conceptualization, Funding acquisition, Resources, Writing – review & editing.
Funding
The author(s) declare financial support was received for the research, authorship, and/or publication of this article. This research was supported by Ningbo Science and Technology Research Projects, China (2024Z276), the earmarked fund for CARS-49, Ningbo Public Welfare Science and Technology Program (2023S123), Natural Science Foundation of Ningbo Government (2023J109), and Zhejiang Provincial Department of Education Scientific Research Project (Y202249030).
Conflict of interest
Author J-LX was employed by the company Fujian Dalai Seed Science and Technology Co., Ltd.
The remaining authors declare that the research was conducted in the absence of any commercial or financial relationships that could be construed as a potential conflict of interest.
Publisher’s note
All claims expressed in this article are solely those of the authors and do not necessarily represent those of their affiliated organizations, or those of the publisher, the editors and the reviewers. Any product that may be evaluated in this article, or claim that may be made by its manufacturer, is not guaranteed or endorsed by the publisher.
Supplementary material
The Supplementary Material for this article can be found online at: https://www.frontiersin.org/articles/10.3389/fmars.2024.1492142/full#supplementary-material
References
1
Alcaide E. Blasco M. D. Esteve C. (2005). Occurrence of drug-resistant bacteria in two European Eel Farms. Appl. Environ. Microb.71, 3348–3350. doi: 10.1128/AEM.71.6.3348-3350.2005
2
Bauer A. W. Kirby W. M. Sherris J. C. Turck M. (1966). Antibiotic susceptibility testing by a standardized single disk method. Am. J. Clin. Pathol.45, 493–496. doi: 10.1093/ajcp/45.4_ts.493
3
Bosi E. Fondi M. Orlandini V. Perrin E. Maida I. de Pascale D. et al . (2017). The pangenome of (Antarctic) Pseudoalteromonas bacteria: evolutionary and functional insights. BMC Genomics18, 93. doi: 10.1186/s12864-016-3382-y
4
Cao J. Y. Kong Z. Y. Zhang Y. F. Ling T. Xu J. L. Liao K. et al . (2019). Bacterial community diversity and screening of growth-affecting bacteria from Isochrysis galbana following antibiotic treatment. Front. Microbiol.10. doi: 10.3389/fmicb.2019.00994
5
Chauhan A. Singh R. (2019). Probiotics in aquaculture: a promising emerging alternative approach. Symbiosis77, 99–113. doi: 10.1007/s13199-018-0580-1
6
Chen Y. A. Chiu W. C. Wang T. Y. Wong H. C. Tang C. T. (2024). Isolation and characterization of an antimicrobial Bacillus subtilis strain O-741 against Vibrio parahaemolyticus. PLoS One19, e0299015. doi: 10.1371/journal.pone.0299015
7
Costa T. S. Copatti C. E. da Silva J. J. Marchao R. S. da Silva R. C. Rocha A. D. et al . (2024). Use of Bacillus subtilis multiplicate in the water used for biofloc formation: Growth, hemato-biochemistry, intestinal bacteria colonies, and bacterial resistance evaluations of Nile tilapia. Aquaculture590, 741039. doi: 10.1016/j.aquaculture.2024.741039
8
Dawood M. A. O. Koshio S. (2016). Recent advances in the role of probiotics and prebiotics in carp aquaculture: A review. Aquaculture454, 243–251. doi: 10.1016/j.aquaculture.2015.12.033
9
Di Costanzo F. Di Dato V. Romano G. (2023). Diatom-bacteria interactions in the marine environment: Complexity, heterogeneity, and potential for biotechnological applications. Microorganisms11, 2967. doi: 10.3390/microorganisms11122967
10
Doan H. V. Hoseinifar S. H. Ringo E. Esteban M. A. Dadar M. Dawood M. A. O. (2020). Host-associated probiotics: A key factor in sustainable aquaculture. Rev. Fish. Sci. Aquac.28, 16–42. doi: 10.1080/23308249.2019.1643288
11
Do Nascimento M. Dublan M. D. Ortiz-Marquez J. C. F. Curatti L. (2013). High lipid productivity of an Ankistrodesmus-Rhizobium artificial consortium. Bioresour. Technol.146, 400–407. doi: 10.1016/j.biortech.2013.07.085
12
Fontoura R. Spada J. C. Silveira S. T. Tsai S. M. Brandelli A. (2008). Purification and characterization of an antimicrobial peptide produced by Pseudomonas sp. strain 4B. World J. Microb. Biot.25, 205–213. doi: 10.1007/s11274-008-9882-4
13
Gómez D. Espinosa E. Bertazzo M. Lucas-Elío P. Solano F. Sanchez-Amat A. (2008). The macromolecule with antimicrobial activity synthesized by Pseudoalteromonas luteoviolacea strains is an l-amino acid oxidase. Appl. Microbiol. Biot.79, 925–930. doi: 10.1007/s00253-008-1499-x
14
Hu Y. R. Li Y. Z. Li Z. M. Chen C. S. Zang J. J. Li Y. W. et al . (2020). Novel insights into the selective breeding for disease resistance to vibriosis by using natural outbreak survival data in Chinese tongue sole (Cynoglossus semilaevis). Aquaculture529, 735670. doi: 10.1016/j.aquaculture.2020.735670
15
Jin W. Y. Jiang L. H. Hu S. Zhu A. Y. (2024). Effects of Lactobacillus plantarum and Bacillus subtilis on growth, immunity and intestinal flora of largemouth bass (Micropterus salmoides). Aquaculture583, 740581. doi: 10.1016/j.aquaculture.2024.740581
16
Jun J. W. Han J. E. Giri S. S. Tang K. F. J. Zhou X. H. Aranguren L. F. et al . (2017). Phage application for the protection from acute hepatopancreatic necrosis disease (AHPND) in Penaeus vannamei. Indian J. Microbiol.28, 114–117. doi: 10.1007/s12088-017-0694-9
17
Kanjan P. Kimtun A. Chaimongkol S. Sakpetch P. (2022). Probiotic Weissella cibaria KY10 derived from digestive tract of healthy shrimp exhibits strong antibacterial effects against Vibrio parahaemolyticus causing AHPND in shrimp. Aquac. Res.53, 2587–2607. doi: 10.1111/are.15777
18
Kesarcodi-Watson A. Kaspar H. Lategan M. J. Gibson L. (2008). Probiotics in aquaculture: The need, principles and mechanisms of action and screening processes. Aquaculture274, 1–14. doi: 10.1016/j.aquaculture.2007.11.019
19
Li Z. Du Q. Y. Jiao T. Y. Zhu Z. Y. Wan X. L. Ju C. W. et al . (2024). Effects of probiotic supplementary bioflocs (Rhodospirillum rubrum, Bacillus subtilis, Providencia rettgeri) on growth, immunity, and water quality in cultures of Pacific white shrimp (Litopenaeus vannamei). Aquaculture591, 741141. doi: 10.1016/j.aquaculture.2024.741141
20
Li S. N. Zhang C. F. Li F. H. Ren N. Q. Ho S. H. (2023). Recent advances of algae-bacteria consortia in aquatic remediation. Crit. Rev. Environ. Sci. Technol.53, 315–339. doi: 10.1080/10643389.2022.2052704
21
Lieke T. Meinelt T. Hoseinifar S. H. Pan B. Straus D. L. Steinberg C. E. W. (2020). Sustainable aquaculture requires environmental-friendly treatment strategies for fish diseases. Rev. Aquacult.12, 943–965. doi: 10.1111/raq.12365
22
Liu B. L. Eltanahy E. E. Liu H. W. Chua E. T. Thomas-Hall S. R. Wass T. J. et al . (2020). Growth-promoting bacteria double eicosapentaenoic acid yield in microalgae. Bioresour. Technol.316, 123916. doi: 10.1016/j.biortech.2020.123916
23
Longeon A. Peduzzi J. Barthélemy M. Corre S. Nicolas J. L. Guyot M. (2004). Purification and partial identification of novel antimicrobial protein from marine bacterium Pseudoalteromonas species strain X153. Mar. Biotechnol.6, 633–641. doi: 10.1007/s10126-004-3009-1
24
López-Cervantes G. Alvarez-Ruiz P. Luna-Suárez S. Luna-González A. Esparza-Leal H. M. Castro-Martínez C. et al . (2021). Temperature and salinity modulate virulence and PirA gene expression of Vibrio parahaemolyticus, the causative agent of AHPND. Aquacult. Int.29, 743–756. doi: 10.1007/s10499-021-00654-0
25
Milton D. L. (2006). Quorum sensing in vibrios: Complexity for diversification. Int. J. Med. Microbiol.296, 61–71. doi: 10.1016/j.ijmm.2006.01.044
26
Muñoz-Cerro K. González R. Mercado A. Lira G. Rojas R. Yáñez C. et al . (2023). Scallop larvae resistant to a pathogenic Vibrio harbor host-associated bacteria with probiotic potential. Aquaculture579, 740217. doi: 10.1016/j.aquaculture.2023.740217
27
Nagappan S. Das P. AbdulQuadir M. Thaher M. Khan S. Mahata C. et al . (2021). Potential of microalgae as a sustainable feed ingredient for aquaculture. J. Biotechnol.341, 1–20. doi: 10.1016/j.jbiotec.2021.09.003
28
Oliver J. D. (2006). “Vibrio vulnificus,” in The biology of vibrios. Eds. ThompsonF. L.AustinB.SwingsJ. (American Society of Microbiology, Washington, DC), 349–366.
29
Osborne B. Siboni N. Seymour J. R. Ralph P. Pernice M. (2023). Exploring the potential of algae-bacteria interactions in the biocontrol of the marine pathogen Vibrio parahaemolyticus. J. Appl. Phycol.35, 2731–2743. doi: 10.1007/s10811-023-03071-3
30
Peng H. X. de-Bashan L. E. Bashan Y. Higgins B. T. (2020). Indole-3-acetic acid from Azosprillum brasilense promotes growth in green algae at the expense of energy storage products. Algal Res.47, 101845. doi: 10.1016/j.algal.2020.101845
31
Qin J. G. Pearson L. Carragher J. F. (1999). Response of Tetraselmis suecica to nutrient and grazer manipulation. J. Appl. Phycol.11, 481–485. doi: 10.1023/A:1008116530154
32
Richards G. P. Watson M. A. Needleman D. S. Uknalis J. Boyd E. F. Fay J. P. (2017). Mechanisms for Pseudoalteromonas piscicida-induced killing of vibrios and other bacterial pathogens. Appl. Environ. Microb.83, 171–175. doi: 10.1128/AEM.00175-17
33
Rico A. Jacobs R. Van den Brink P. J. Tello A. (2017). A probabilistic approach to assess antibiotic resistance development risks in environmental compartments and its application to an intensive aquaculture production scenario. Environ. pollut.231, 918–928. doi: 10.1016/j.envpol.2017.08.079
34
Seymour J. R. Amin S. A. Raina J. B. Stocker R. (2017). Zooming in on the phycosphere: the ecological interface for phytoplankton-bacteria relationships. Nat. Microbiol.2, 17065. doi: 10.1038/nmicrobiol.2017.65
35
Shen Y. Gao J. Q. Li L. S. (2017). Municipal wastewater treatment via co-immobilized microalgal-bacterial symbiosis: Microorganism growth and nutrients removal. Bioresour. Technol.243, 905–913. doi: 10.1016/j.biortech.2017.07.041
36
Singh S. S. Akhtar M. N. Sharma D. Mandal S. M. Korpole S. (2021). Characterization of iturin V, a novel antimicrobial lipopeptide from a potential probiotic strain lactobacillus sp. M31. Probiotics Antimicro.13, 1766–1779. doi: 10.1007/s12602-021-09796-2
37
Stevick R. J. Sohn S. Modak T. H. Nelson D. R. Rowley D. C. Tammi K. et al . (2019). Bacterial community dynamics in an oyster hatchery in response to probiotic treatment. Front. Microbiol.10. doi: 10.3389/fmicb.2019.01060
38
Takyi E. Stevick R. J. Witkop E. M. Gregg L. Chesler-Poole A. Small J. M. et al . (2024). Probiotic treatment modulates the bacterial microbiome of larval eastern oysters, Crassostrea virginica, in hatcheries. Aquaculture583, 740624. doi: 10.1016/j.aquaculture.2024.740624
39
Wang D. Flint S. H. Palmer J. S. Gagic D. Fletcher G. C. On S. L. W. (2022). Global expansion of Vibrio parahaemolyticus threatens the seafood industry: Perspective on controlling its biofilm formation. Lwt-Food Sci. Technol.158, 113182. doi: 10.1016/j.lwt.2022.113182
40
Wang R. X. Guo Z. H. Tang Y. P. Kuang J. W. Duan Y. F. Lin H. Z. et al . (2020a). Effects on development and microbial community of shrimp Litopenaeus vannamei larvae with probiotics treatment. AMB Express10, 109. doi: 10.1186/s13568-020-01041-3
41
Wang Y. B. Li J. R. Lin J. D. (2008). Probiotics in aquaculture: Challenges and outlook. Aquaculture281, 1–4. doi: 10.1016/j.aquaculture.2008.06.002
42
Wang D. D. Li J. H. Zhu G. L. Zhao K. Jiang W. W. Li H. D. et al . (2020b). Mechanism of the potential therapeutic candidate Bacillus subtilis BSXE-1601 against shrimp pathogenic Vibrios and multifunctional metabolites biosynthetic capability of the Strain as predicted by genome analysis. Front. Microbiol.11. doi: 10.3389/fmicb.2020.581802
43
Wang A. R. Ran C. Wang Y. B. Zhang Z. Ding Q. W. Yang Y. L. et al . (2019). Use of probiotics in aquaculture of China-a review of the past decade. Fish Shellfish Immunol.86, 734–755. doi: 10.1016/j.fsi.2018.12.026
44
Wang H. L. Sun B. C. Xie G. S. Wan X. Y. Huang J. Song X. L. (2021). Spotlight on a novel bactericidal mechanism and a novel SXT/R391-like integrative and conjugative element, carrying multiple antibiotic resistance genes, in Pseudoalteromonas flavipulchra strain CDM8. Microbiol. Res.242, 126598. doi: 10.1016/j.micres.2020.126598
45
Wei C. Luo K. Wang M. Y. Li Y. M. Pan M. J. Xie Y. M. et al . (2022). Evaluation of potential probiotic properties of a strain of lactobacillus plantarum for shrimp farming: from beneficial functions to safety assessment. Front. Microbiol.13. doi: 10.3389/fmicb.2022.854131
46
Wu M. N. Cao J. Y. Xu Y. J. Xu S. M. Zhou Z. B. Shao M. M. et al . (2023). Impact of three phycospheric bacterial strains on the growth and fatty acid composition of Isochrysis galbana. Alagl Res.74, 103183. doi: 10.1016/j.algal.2023.103183
47
Xu L. T. Jiang M. W. Peng R. B. Jiang X. M. Wang S. Y. Han Q. X. et al . (2024). The pathogen Vibrio alginolyticus H1 and its antagonist Pseudoalteromonas piscicida H2 associated with the health status of cuttlefish Sepia pharaonis. Comp. Immunol. Rep.6, 200141. doi: 10.1016/j.cirep.2024.200141
48
Yilmaz S. Yilmaz E. Dawood M. A. O. Ringo E. Ahmadifar E. Abdel-Latif H. M. R. (2022). Probiotics, prebiotics, and synbiotics used to control vibriosis in fish: A review. Aquaculture547, 737514. doi: 10.1016/j.aquaculture.2021.737514
49
Zhang J. X. Ran Z. S. Xie H. X. Kong F. Zhang M. Q. Zhou Y. et al . (2023). A systematic analysis and evaluation of nutritional composition of 23 strains of marine microalgae commonly used in aquaculture. Algal Res.72, 103122. doi: 10.1016/j.algal.2023.103122
50
Zhao S. S. Zhang H. J. Cai X. L. Wang L. R. Shen X. R. Cao Z. et al . (2023). Study on antibacterial and quorum quenching activity of a Pseudoalteromonas sp. DL3. Acta Agriculturae Zhejiangensis35, 50–57. doi: 10.3969/j.issn.1004-1524.2023.01.06
Summary
Keywords
microalgae growth-promoting bacteria, Pseudoalteromonas flavipulchra , Vibrio , antibacterial activity, antibacterial substance
Citation
Wu M-n, Xu Y-j, Shao M-m, Wang Z-y, Cao J-y and Xu J-l (2024) Pseudoalteromonas flavipulchra as a dual-functional probiotic for aquaculture: enhancing microalgae growth and antagonizing Vibrio pathogens. Front. Mar. Sci. 11:1492142. doi: 10.3389/fmars.2024.1492142
Received
06 September 2024
Accepted
21 October 2024
Published
12 November 2024
Volume
11 - 2024
Edited by
Peng Jin, University of Guangzhou, China
Reviewed by
Jinlin Liu, Tongji University, China
Zhanyou Chi, Dalian University of Technology, China
Updates
Copyright
© 2024 Wu, Xu, Shao, Wang, Cao and Xu.
This is an open-access article distributed under the terms of the Creative Commons Attribution License (CC BY). The use, distribution or reproduction in other forums is permitted, provided the original author(s) and the copyright owner(s) are credited and that the original publication in this journal is cited, in accordance with accepted academic practice. No use, distribution or reproduction is permitted which does not comply with these terms.
*Correspondence: Jia-yi Cao, caojiayi@nbu.edu.cn; Ji-lin Xu, xujilin@nbu.edu.cn
Disclaimer
All claims expressed in this article are solely those of the authors and do not necessarily represent those of their affiliated organizations, or those of the publisher, the editors and the reviewers. Any product that may be evaluated in this article or claim that may be made by its manufacturer is not guaranteed or endorsed by the publisher.